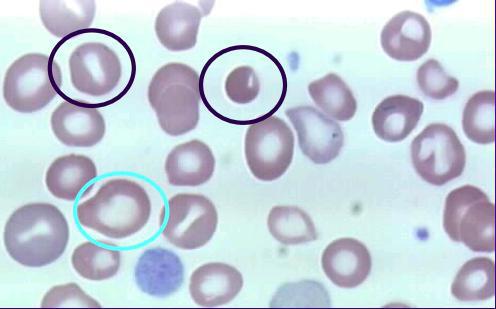

Анизоцитоз тромбоцитов — состояние, при котором размеры тромбоцитов в крови изменяются. Это может указывать на различные заболевания и нарушения. В статье рассмотрим, что такое анизоцитоз, как его определяют в общем анализе крови и какие клинические значения имеют изменения в размере тромбоцитов. Понимание этого термина поможет читателям лучше интерпретировать результаты анализов и при необходимости обратиться за медицинской помощью.
Причины
Анизоцитоз в общем анализе крови может возникать по нескольким причинам:
- Неправильное питание. Хотя значительных изменений в показателях кровяных клеток не наблюдается, недостаток витаминов и железа может возникнуть из-за скромного рациона или определенных продуктов. Особенно подвержены этому дети с пониженным аппетитом. Для улучшения показателей рекомендуется включить в рацион мясные и рыбные блюда, свежие овощи и фрукты. Витамин В12 способствует увеличению количества эритроцитов, а витамин А помогает восстановить нормальные размеры клеток.
- Переливание крови. Перед процедурой донорская кровь должна быть тщательно проверена на наличие аномальных форменных элементов. В противном случае реципиент может получить кровь с клетками, отличающимися по размеру. Иммунной системе требуется время для устранения этих элементов, и со временем все клетки крови принимают нормальные размеры.
- Онкологические заболевания. Атипичные клетки могут поражать костный мозг, что приводит к образованию измененных кровяных телец.
- Заболевания печени, включая раковые опухоли, которые метастазируют в этот орган. В таких случаях чаще всего наблюдается макроцитоз.
- Заболевания щитовидной железы. Анизоцитоз может быть вызван аутоиммунным тиреоидитом, узловым зобом и злокачественными новообразованиями.
- Нарушения в процессе выработки гемоглобина.
- Состояния, сопровождающиеся нарушением нормального соотношения между созревающими и отмирающими кровяными клетками. Анизоцитоз такого типа чаще встречается у пожилых людей.
- Длительное и систематическое употребление алкоголя.
- Инфекционные заболевания и глистные инвазии.
В зависимости от типа клеток, которые претерпевают изменения, анизоцитоз классифицируется на следующие виды:
- Анизоцитоз тромбоцитов — это увеличение размеров клеток, отвечающих за свертывание крови. Для этой формы патологии необходимо провести тщательное обследование. Диагностический план включает анализ крови на наличие признаков анемии, инфекций, лейкоза и лучевой болезни.
- Анизоцитоз эритроцитов. Этот тип патологии характеризуется изменением размеров красных кровяных телец, которые отвечают за транспортировку кислорода к органам и тканям, а также за выведение углекислого газа. Эритроциты также участвуют в доставке питательных веществ. Изменение их размеров может указывать на заболевания печени и наличие В12-дефицитной анемии.
Анизоцитоз тромбоцитов, проявляющийся в общем анализе крови, вызывает значительное внимание врачей. Специалисты отмечают, что данное состояние характеризуется изменением размеров тромбоцитов, что может свидетельствовать о различных патологиях. Врачи подчеркивают, что анизоцитоз может быть признаком нарушений в костном мозге, а также указывать на наличие хронических заболеваний или дефицит витаминов.
При интерпретации результатов анализа важно учитывать сопутствующие симптомы и клиническую картину пациента. Врачи рекомендуют проводить дополнительные исследования для выяснения причины анизоцитоза и назначения адекватного лечения. В целом, анизоцитоз тромбоцитов является важным маркером, который может помочь в диагностике и мониторинге состояния здоровья пациента.
https://youtube.com/watch?v=s7SbGMQkpts
Микроцитоз
В этом случае в крови у взрослых и детей можно выявить кровяные клетки, размеры которых не превышают 6,5 мкм. Основные причины появления микроанизоцитоза включают:
- наследственные заболевания системы кроветворения;
- анемию, вызванную дефицитом железа;
- талассемию.
| Показатель | Описание | Клиническое значение |
|---|---|---|
| MPV (Mean Platelet Volume) | Средний объем тромбоцитов | Повышение может указывать на активное тромбоцитопоэз, разрушение тромбоцитов, миелопролиферативные заболевания. Снижение — на гипоплазию костного мозга, апластическую анемию. |
| PDW (Platelet Distribution Width) | Ширина распределения тромбоцитов по объему | Отражает степень анизоцитоза тромбоцитов. Повышение указывает на неоднородность размеров тромбоцитов, что может быть при тромбоцитопении, тромбоцитозе, миелопролиферативных заболеваниях. |
| P-LCR (Platelet-Large Cell Ratio) | Отношение крупных тромбоцитов к общему числу тромбоцитов | Повышение указывает на увеличение доли крупных тромбоцитов, что может быть при активном тромбоцитопоэзе, разрушении тромбоцитов, миелопролиферативных заболеваниях. |
| PCT (Plateletcrit) | Тромбокрит (объем, занимаемый тромбоцитами в крови) | Отражает общую массу тромбоцитов. Повышение может быть при тромбоцитозе, снижение — при тромбоцитопении. |
| Анизоцитоз тромбоцитов | Наличие тромбоцитов различных размеров | Может быть признаком различных патологий, от доброкачественных до злокачественных. Требует дальнейшего обследования. |
Макроцитоз
Данная форма заболевания проявляется преобладанием макроцитов, которые представляют собой клетки с размерами, значительно превышающими нормальные показатели. Макроцитоз часто наблюдается у новорожденных и считается нормальным состоянием. В течение 14-60 дней размеры клеток приходят в норму. К патологическим причинам данного явления можно отнести:
- онкологические болезни;
- повышенную активность щитовидной железы;
- миелопролиферативные расстройства;
- нарушения работы печени;
- нехватку витамина В12 и фолиевой кислоты.
https://youtube.com/watch?v=LMNY8M9TRKk
Мегалоцитоз
В таком случае в анализе крови у ребенка или взрослого можно обнаружить клетки, размеры которых превышают 12 мкм. Эти клетки имеют однородную окраску (без просветления в центре) и овальную форму. Мегалоцитоз может развиваться под влиянием следующих факторов:
- снижение уровня гемоглобина у женщин в период беременности;
- нехватка витаминов и питательных веществ в организме;
- наличие гельминтов и инфекций, вызванных внутриклеточными паразитами;
- дизэритропоэз (нарушение процесса созревания эритроцитов).
Смешанный анизоцитоз
Анизоцитоз смешанного типа проявляется наличием как увеличенных, так и уменьшенных кровяных клеток. В этом состоянии макроциты и микроциты могут встречаться в равных пропорциях.
При этом один из типов клеток может доминировать над другим.
Наиболее часто встречается микроцитарный вариант данной патологии, при котором количество уменьшенных клеток превышает количество увеличенных.
Степени выраженности
Данный показатель анизоцитоза определяется на основе количества клеток с измененной формой.
Незначительный
Эта степень анизоцитоза определяется наличием не более 25% измененных клеток крови и проявлением слабо выраженных симптомов. Заболевание развивается на фоне легкого дефицита витаминов, несбалансированного питания и потери крови.
Умеренный
В этом случае доля клеток, размеры которых отличаются от нормы, составляет от 25 до 50% от общего числа тромбоцитов или эритроцитов. Наблюдаются умеренно выраженные симптомы. Данная патология нуждается в медикаментозной коррекции. Умеренный анизоцитоз смешанного типа, с преобладанием микроцитов, возникает на фоне заболеваний печени, инфекционных процессов и гельминтозов.
Выраженный
Если в лабораторном анализе указано обозначение «+++», это свидетельствует о значительном анизоцитозе. В данном случае клетки, размеры которых отличаются от нормальных, преобладают над здоровыми кровяными элементами. Такой результат анализа часто наблюдается у пациентов с серьезными заболеваниями кроветворной системы и онкологическими недугами.
Критический
В этом случае почти все здоровые компоненты крови заменяются аномальными. Данное патологическое состояние представляет серьезную угрозу для жизни пациента, поэтому диагностика и терапия должны начинаться без промедления.
Признаки
При незначительном и умеренном анизоцитозе состояние пациента ухудшается лишь немного. Появляются симптомы, которые не характерны для данной болезни. В случае выраженного анизоцитоза можно наблюдать следующие проявления:
- постоянная мышечная слабость, которая не проходит даже после длительного отдыха или ночного сна;
- снижение как физической, так и умственной активности;
- умеренные головные боли, локализующиеся в области темени или затылка;
- повышенная сонливость в течение дня;
- тремор конечностей, который возникает после пробуждения.
Если заболевание не лечить длительное время, оно может прогрессировать, и к перечисленным симптомам добавятся более серьезные проявления, такие как кардиологический синдром. Основные признаки выраженного и критического анизоцитоза включают:
- учащение пульса;
- увеличение частоты сердечных сокращений;
- затрудненное дыхание (одышка, приступы удушья);
- ощущение нехватки воздуха, возникающее в любое время суток и не зависящее от физической активности;
- бледность кожи, губ и слизистых оболочек рта (в тяжелых случаях ткани могут приобретать синюшный оттенок).
Особенности протекания у беременных
Незначительный анизоцитоз, при котором наблюдается преобладание микроцитов и макроцитов, часто встречается у женщин в период беременности. Это явление связано с развитием анемии или гиповитаминоза, которые могут возникнуть из-за несоблюдения рекомендаций по правильному питанию и недостаточного приема витаминных добавок. Клинические проявления могут включать следующие симптомы:
- бледность кожи и слизистых оболочек;
- головокружение;
- общая слабость и апатия;
- снижение аппетита;
- ухудшение состояния волос и ногтей.
У детей
Анизоцитоз в крови может быть выявлен у детей любого возраста. Чаще всего это состояние связано с перенесенными инфекциями или вакцинацией. Ослабление иммунной системы может привести к дефициту железа или витамина В12, что вызывает незначительные изменения в размерах клеток. Обратиться к врачу следует, если данное состояние сопровождается такими симптомами:
- бледность кожи и слизистых оболочек;
- ломкость волос и расслоение ногтей;
- сухость кожи;
- нарушения пищеварения, когда запоры чередуются с диареей;
- частое появление язв на слизистых рта;
- повышенная утомляемость и раздражительность;
- ухудшение состояния зубов и изменение восприятия вкуса;
- учащенное сердцебиение.
Диагностика
Для выявления анизоцитоза тромбоцитов достаточно провести лабораторное исследование мазка крови, однако для получения более подробной информации рекомендуется выполнить общеклинический анализ крови.
В процессе анализа создается тромбоцитарная гистограмма — графическое представление количества и качества тромбоцитов в образце. Интерпретацией полученных данных занимается врач-гематолог, но для определения причины проблемы следует обратиться к терапевту или семейному врачу.
Для установления причины расстройства необходимо провести комплексное обследование организма, которое начинается с следующих шагов:
- анализ истории болезни — поможет выявить основной патологический источник изменений;
- сбор и оценка жизненного анамнеза — для обнаружения факторов, не связанных с наличием какого-либо заболевания;
- оценка общего состояния пациента — особое внимание специалист уделяет состоянию кожных покровов;
- перкуссия и пальпация живота — позволит определить наличие гепатоспленомегалии;
- измерение показателей сердечного ритма и артериального давления;
- тщательный опрос пациента — для выяснения степени выраженности основных клинических проявлений и составления полной картины симптомов.
Кроме того, потребуется провести ряд лабораторно-инструментальных исследований и консультации специалистов из различных областей медицины. Такая диагностическая программа разрабатывается индивидуально для каждого пациента.
Лечение
При выявлении анизоцитоза тромбоцитов важно устранить основное заболевание, которое его вызывает. В некоторых ситуациях для этого достаточно:
- скорректировать питание;
- тщательно выбирать доноров для переливания крови;
- разнообразить рацион продуктами, содержащими железо и другие полезные вещества;
- принимать витаминно-минеральные добавки.
В других случаях подход к лечению будет индивидуальным. Например:
- при наличии онкологических заболеваний может потребоваться хирургическое вмешательство, лучевая терапия или химиотерапия;
- для заболеваний щитовидной железы применяются гормональные препараты или операции;
- если в организм попадают инфекционные агенты, то необходимы антибиотики, диетическое питание, физиотерапия и другие консервативные методы.
Признаки выздоровления включают несколько факторов — улучшение общего состояния, полное исчезновение симптомов и изменения в результатах общеклинического анализа крови.
Профилактика
Чтобы предотвратить анизоцитоз тромбоцитов, рекомендуется следовать следующим рекомендациям:
- сбалансированное питание (включение в рацион продуктов, богатых железом и витамином В12);
- регулярное проведение общего анализа крови;
- отказ от курения и употребления алкогольных напитков;
- профилактика инфекционных и паразитарных заболеваний;
- увеличение физической активности (умеренные физические нагрузки положительно сказываются на обмене веществ, что способствует улучшению состава крови).
При возникновении таких симптомов, как слабость, повышенная утомляемость и бледность кожи, следует обратиться к врачу.
Анизоцитоз тромбоцитов является довольно редким состоянием, так как чаще наблюдаются изменения в размерах эритроцитов. Параметр PDW отражает степень отклонения объемов форменных элементов крови от нормальных значений, которые составляют 14 – 18 %.
В большинстве случаев данное отклонение связано с патологическими процессами в организме. К примеру, это может быть миелодиспластический синдром, онкологические заболевания или паразитарные инфекции.
Среди характерных клинических проявлений анизоцитоза можно выделить слабость, быструю утомляемость, учащенное сердцебиение и выраженную бледность кожи.
Анизоцитоз выявляется только в ходе общего анализа крови, который необходимо проводить как взрослым, так и детям. Однако полученных данных зачастую недостаточно для определения первопричины, поэтому процесс диагностики должен включать как лабораторные, так и инструментальные исследования.
Ситуации, когда уровень показателя понижен или повышен, обычно устраняются в процессе лечения основного заболевания — терапия может быть как консервативной, так и хирургической, или же комплексной.
Этиология
Анизоцитоз тромбоцитов представляет собой изменение размеров или форм клеток. Это состояние характеризуется наличием в крови тромбоцитов различных объемов, что можно определить, изучая их распределение.
Нормальным считается содержание измененных клеток в диапазоне от 14 до 18 %. Допускается небольшое отклонение в 1-2 % в ту или иную сторону, что может быть связано с индивидуальными особенностями организма.
Увеличение размера тромбоцитов может быть вызвано следующими факторами:
- нехватка железа или витаминов;
- онкологические заболевания, при которых метастазы проникают в костный мозг;
- миелодиспластический синдром;
- переливание крови;
- наличие воспалительных или инфекционных заболеваний, приводящих к сильной интоксикации;
- гемотрансфузия;
- паразитарные инвазии;
- повреждение сосудистых стенок;
- восстановление после хирургических вмешательств;
- удаление селезенки;
- длительный прием кортикостероидов;
- аутоиммунная тромбоцитопения.
Индекс анизоцитоза может снижаться при следующих состояниях:
- лейкемии;
- апластической анемии;
- лучевой болезни;
- длительном лечении цитостатиками;
- тромбоцитопатиях;
- спленомегалии;
- сепсисе;
- мегалобластной анемии;
- заболеваниях накопления, таких как болезнь Ниманна-Пика или Гоше;
- гемолитико-уремическом синдроме;
- хроническом гепатите;
- циррозе печени;
- ДВС-синдроме.
Переливание крови может стать предрасполагающим фактором как у детей, так и у взрослых. Важно отметить, что в таких случаях анизоцитоз обычно имеет временный характер, и показатели возвращаются к норме самостоятельно.
Классификация
Специалисты в области медицины выделяют несколько уровней тяжести протекания заболевания, что приводит к следующим классификациям:
-
- или легкая форма — в таких случаях изменения затрагивают не более 25 % клеток крови;
- ++ или средняя форма — болезнь охватывает 50 % тромбоцитов;
- +++ или тяжелая форма — количество измененных клеток превышает здоровые, достигая 75 %;
- ++++ — крайне тяжелая или критическая форма, при которой все клетки подлежат замещению.
В зависимости от степени изменений форменных элементов крови расстройство классифицируется следующим образом:
- микроцитоз — наблюдается уменьшение размера тромбоцитов;
- макроцитоз — ситуация противоположная (размеры клеток увеличены);
- смешанный тип — характеризуется тем, что доля макроцитов и микроцитов составляет не менее 50 %, при этом макроциты имеют объем от 8 микрометров и выше, а микроциты — не более 6,9 микрометра.
Симптоматика
Анизоцитоз тромбоцитов может быть выявлен не только на основе общеклинического анализа крови, но и по ряду внешних признаков. Основная сложность заключается в том, что симптомы могут проявляться слабо или скрываться за проявлениями основного заболевания. В результате, данная аномалия часто остается незамеченной.
Клинические проявления могут включать:
- учащенное сердцебиение и одышку — эти симптомы могут возникать даже в состоянии покоя;
- чувство усталости и быструю утомляемость — зачастую это наиболее заметные внешние проявления;
- бледность кожи, слизистых оболочек, глаз и ногтей;
- постоянную сонливость и мышечную слабость;
- снижение концентрации внимания;
- головные боли;
- повышенную чувствительность кожи к внешним раздражителям;
- увеличение печени и селезенки;
- изменения в вкусовых предпочтениях;
- эмоциональную нестабильность;
- акроцианоз — легкое посинение кожи.
Эти симптомы могут наблюдаться как у взрослых, так и у детей, часто дополняясь проявлениями основного заболевания. При появлении одного или нескольких из перечисленных признаков рекомендуется как можно скорее обратиться за консультацией к врачу.
Профилактика и прогноз
Чтобы предотвратить возникновение проблемы, достаточно следовать нескольким простым рекомендациям. Профилактические советы:
- полный отказ от вредных привычек;
- сбалансированное и полноценное питание;
- регулярные прогулки на свежем воздухе;
- постоянное укрепление иммунной системы;
- избегание как физического, так и эмоционального перенапряжения;
- регулярные профилактические осмотры в медицинских учреждениях.
Независимо от того, наблюдается ли пониженный или повышенный уровень форменных элементов крови, прогноз будет зависеть от этиологического фактора. Важно помнить, что каждая основная болезнь имеет свои возможные осложнения.
Анизоцитоз — это состояние, при котором размеры красных кровяных клеток варьируются. Эритроциты могут иметь различный диаметр. Более подробно мы рассмотрим этот вопрос в данной статье.
В анализах этот показатель обозначается аббревиатурой RDW. Это индекс эритроцитов, который принято называть показателем неоднородности красных клеток в объеме. Если расшифровать данную аббревиатуру, то она означает ширину распределения эритроцитов. Анизоцитоз указывает на наличие в организме определенной патологии.
https://youtube.com/watch?v=wcRC-2Qxgcs
Изменение размеров эритроцитов и тромбоцитов
Врачи при оценке состояния здоровья пациента учитывают не только количественные показатели крови. После проведения общего анализа можно получить представление о происходящих в организме процессах, основываясь на размерах и форме эритроцитов и тромбоцитов. Анизоцитоз — это специфическое нарушение, которое может наблюдаться как у взрослых, так и у детей. Оно связано с изменением размеров кровяных клеток и может сигнализировать о наличии заболеваний, что делает необходимым проведение дополнительных исследований и назначение соответствующего лечения.
Отличительные признаки заболевания
Как определить анизоцитоз в общем анализе крови? В крови человека присутствуют тромбоциты, которые отвечают за процесс свертывания, а также лейкоциты, известные как белые кровяные клетки, играющие ключевую роль в защите организма от инфекций и чуждых веществ. Эритроциты, в свою очередь, имеют важное значение для жизнедеятельности, так как они переносят кислород и питательные вещества к клеткам, а также выводят углекислый газ. Эти клетки имеют различное строение и форму, что означает, что они представлены в разных размерах:
- Нормоциты — это клетки размером от семи до девяти микрометров.
- Микроциты или микроэритроциты — клетки, размер которых не превышает семи микрометров.
- Макроциты — клетки размером от восьми микрометров.
- Мегалоциты — клетки, размер которых составляет двенадцать микрометров и более.
При нормальных показателях эритроцитов в крови и хорошем состоянии здоровья количество нормоцитов не превышает семидесяти процентов от общего числа эритроцитов, в то время как макроциты и микроциты составляют в сумме до пятнадцати процентов. Если в процессе анализа обнаруживается, что какой-либо из показателей превышает норму или, наоборот, ниже установленного уровня, это может указывать на наличие нарушений в организме. Увеличение показателя RDW связано с ростом количества как крупных, так и мелких клеток. Аналогичные изменения могут наблюдаться и у тромбоцитов. Иными словами, у пациента происходят изменения, связанные с размерами кровяных клеток.
Из определения следует, что анизоцитоз в общем анализе крови представляет собой изменение размеров эритроцитов и тромбоцитов. Если это нарушение выражено слабо, рекомендуется провести дополнительные исследования, чтобы исключить вероятность серьезных заболеваний. Снижение уровня гемоглобина в красных кровяных клетках может привести к анемии. Тем не менее, важно тщательно контролировать состояние крови, чтобы исключить более серьезные отклонения.
Стадии и виды анизоцитоза
Анизоцитоз представляет собой отклонение от нормальных показателей, которое можно классифицировать по степеням в зависимости от его выраженности:
- 1-я степень — легкая или умеренная, при которой в крови содержится от тридцати до пятидесяти процентов микроцитов или макроцитов.
- 2-я степень — средняя, в которой доля микроцитов или макроцитов составляет от пятидесяти до семидесяти процентов.
- 3-я степень — тяжелая или выраженная, когда более семидесяти процентов эритроцитов составляют микроциты или макроциты.
Анизоцитоз смешанного типа
При смешанном типе изменения размеров кровяных клеток общее количество макро- и микроцитов в крови не превышает 50%. Для выявления этого состояния можно использовать кривую Прайса-Джонса. В случае смешанного анизоцитоза в крови будут преобладать макроциты. Чаще всего диагностируются либо пернициозная анемия, либо анемия, связанная с нехваткой витамина В12.
Нормальный уровень RDW составляет в среднем от четырнадцати до восемнадцати процентов. Отклонения от этого показателя, возникающие из-за уменьшения или увеличения размеров тромбоцитов, могут быть как легкой, так и средней степени тяжести.
Основание развития
Размеры тромбоцитов могут варьироваться по различным причинам. При миелонеопластических заболеваниях наблюдается значительное увеличение диаметра этих клеток. В то же время, размеры тромбоцитов уменьшаются при синдроме диссеминированного внутрисосудистого свертывания, апластической анемии, нарушениях функции печени, лейкемии и ряде других заболеваний. Изолированный анизоцитоз эритроцитов может проявляться на ранних стадиях анемии и иногда возникает во время менструаций, если они продолжаются дольше обычного.
Изменение размеров эритроцитов чаще всего является одним из признаков анемии. Этот диагноз нередко ставят детям. Отклонения в размерах клеток часто рассматриваются как симптом гипохромии, постгеморрагической анемии или хлороза, что свидетельствует о дегенеративных процессах в крови. Данный синдром не является самостоятельным заболеванием. К другим причинам возникновения анизоцитоза можно отнести:
- недостаток витамина А;
- дефицит витамина В12 и железа;
- переливание крови.
В последнем случае анизоцитоз проходит самостоятельно. Организм адаптируется к «обновленной» крови, заменяя поврежденные клетки на здоровые.
Симптомы отклонения
Анизоцитоз — это состояние, которое чаще всего указывает на наличие анемии. Симптоматика может быть схожа. Явные проявления данного состояния могут напоминать симптомы сердечной недостаточности. Если вы заметили следующие признаки, рекомендуется обратиться к врачу и пройти общий анализ крови:
- быстрая утомляемость;
- снижение работоспособности;
- ухудшение концентрации внимания;
-
невозможность заниматься физической активностью;
-
ощущение слабости и упадка сил;
- одышка, возникающая как при физической нагрузке, так и в покое, периодически;
- учащенное сердцебиение без видимых причин;
- усиление сердечных сокращений;
- бледность кожи;
- бледный цвет ногтей;
- бледность глаз;
- головные боли;
- шум в ушах;
- изменения в аппетите и нарушенный сон;
- снижение полового влечения;
- нарушения чувствительности кожи.
При возникновении этих симптомов важно обратиться к врачу.
Проведение диагностики
Как определяется анизоцитоз? Нормальные значения были упомянуты ранее.
Основным методом диагностики является общий анализ крови, который предоставляет информацию по всем ключевым показателям. В этом анализе содержится информация о составе крови, а также данные о количестве эритроцитов и тромбоцитов, что необходимо для выявления анизоцитоза. Эритроцитарный индекс можно определить по строке, обозначаемой как коэффициент вариации объема эритроцитов и среднее отклонение объема этих клеток. Для анализа тромбоцитов важна строка, содержащая средний объем тромбоцита и показатель анизоцитоза тромбоцитов.
Способы и методы лечения
Врачи настоятельно советуют каждому пациенту как можно скорее пересмотреть свой рацион и включить в него необходимые витамины и минералы. Нежелательные продукты следует исключить из питания, чтобы организм не расходовал свои силы на «очищение» от их токсичных остатков.
При отсутствии серьезных заболеваний достаточно внести изменения в питание и образ жизни, а также избавиться от вредных привычек и обеспечить себе полноценный сон, чтобы помочь организму справиться с анизоцитозом. Часто специалисты рекомендуют принимать добавки, содержащие железо и витамин B12, так как их уровень в организме может быть недостаточным.
Влияние на коагуляцию
Анизоцитоз тромбоцитов, характеризующийся наличием тромбоцитов различного размера в периферической крови, может оказывать значительное влияние на коагуляцию. Тромбоциты, или кровяные пластинки, играют ключевую роль в гемостазе, процессе, который предотвращает кровотечения и способствует заживлению поврежденных сосудов. Изменения в их размере могут указывать на различные патологические состояния и влиять на их функциональную активность.
При анизоцитозе наблюдается наличие как мелких, так и крупных тромбоцитов, что может быть связано с различными заболеваниями, такими как анемия, миелодиспластические синдромы или тромбоцитопения. Мелкие тромбоциты, как правило, менее активны и менее эффективны в процессе агрегации, что может привести к увеличению времени свертывания крови и повышенному риску кровотечений. В то же время, крупные тромбоциты, хотя и обладают большей агрегационной способностью, могут быть менее стабильными и более подвержены разрушению.
Изменение соотношения между мелкими и крупными тромбоцитами может также влиять на уровень фактора Виллебранда, который необходим для нормального функционирования тромбоцитов. При анизоцитозе может наблюдаться снижение уровня этого фактора, что дополнительно усугубляет проблемы с коагуляцией. Важно отметить, что анизоцитоз тромбоцитов может быть как первичным, так и вторичным, в зависимости от основного заболевания, что требует комплексного подхода к диагностике и лечению.
Для оценки влияния анизоцитоза на коагуляцию необходимо проводить дополнительные исследования, такие как тесты на агрегацию тромбоцитов, определение уровня фактора Виллебранда и другие коагулограммы. Эти тесты помогут установить степень нарушения гемостаза и выбрать соответствующую терапию. Важно также учитывать, что анизоцитоз может быть лишь одним из множества факторов, влияющих на коагуляцию, и его наличие требует внимательного анализа в контексте общего состояния пациента.
Связь с другими заболеваниями
Анизоцитоз тромбоцитов, характеризующийся изменением размеров тромбоцитов в периферической крови, может быть связан с различными заболеваниями и состояниями организма. Изменения в размере тромбоцитов могут указывать на нарушения в их образовании, функции или разрушении, что в свою очередь может быть следствием различных патологий.
Одним из наиболее распространенных заболеваний, связанных с анизоцитозом тромбоцитов, является мегалобластная анемия. При этом состоянии наблюдается увеличение размеров тромбоцитов, что связано с нарушением их образования в костном мозге. Мегалобластная анемия может быть вызвана дефицитом витамина B12 или фолиевой кислоты, что приводит к нарушению нормального процесса кроветворения.
Кроме того, анизоцитоз тромбоцитов может наблюдаться при различных формах тромбоцитопении, когда количество тромбоцитов в крови снижается. В таких случаях увеличение размеров оставшихся тромбоцитов может быть компенсаторной реакцией организма на снижение их общего числа. Тромбоцитопения может быть вызвана аутоиммунными заболеваниями, инфекциями, а также лекарственными препаратами.
Заболевания печени, такие как цирроз, также могут приводить к анизоцитозу тромбоцитов. Печень играет ключевую роль в синтезе тромбоцитарных факторов, и ее дисфункция может нарушать нормальное образование и регуляцию тромбоцитов. В таких случаях анизоцитоз может сочетаться с другими изменениями в анализе крови, такими как увеличение уровня билирубина и изменение показателей печеночных проб.
Некоторые онкологические заболевания, включая миелодиспластические синдромы и лейкемии, также могут проявляться анизоцитозом тромбоцитов. В этих случаях изменения в размерах тромбоцитов могут быть связаны с нарушением нормального кроветворения и изменениями в костном мозге. Анизоцитоз может быть одним из признаков более серьезных нарушений, требующих дальнейшего обследования и лечения.
Таким образом, анизоцитоз тромбоцитов является важным клиническим признаком, который может указывать на наличие различных заболеваний. Для точной диагностики и определения причины анизоцитоза необходимо учитывать не только размеры тромбоцитов, но и другие показатели общего анализа крови, а также проводить дополнительные исследования, направленные на выявление основного заболевания.
Прогноз и последствия анизоцитоза
Анизоцитоз тромбоцитов, характеризующийся изменением размера тромбоцитов в периферической крови, может иметь различные прогнозы и последствия в зависимости от основного заболевания, вызвавшего это состояние. Важно отметить, что анизоцитоз сам по себе не является диагнозом, а лишь симптомом, который может указывать на наличие различных патологий.
Прогноз при анизоцитозе тромбоцитов зависит от причины его возникновения. Например, если анизоцитоз вызван временными факторами, такими как стресс или физическая нагрузка, то прогноз может быть благоприятным, и нормализация размеров тромбоцитов произойдет после устранения этих факторов. Однако если анизоцитоз является следствием более серьезных заболеваний, таких как миелодиспластический синдром, лейкемия или другие нарушения гемопоэза, прогноз может быть менее оптимистичным.
Последствия анизоцитоза могут варьироваться в зависимости от степени выраженности и сопутствующих изменений в анализе крови. Увеличение размеров тромбоцитов может указывать на их повышенную активность, что может привести к повышенному риску тромбообразования. Это, в свою очередь, может вызвать такие осложнения, как тромбофлебит, инсульт или инфаркт миокарда. С другой стороны, наличие мелких тромбоцитов может свидетельствовать о снижении их функциональной активности, что может привести к повышенному риску кровотечений и гематом.
Важно также учитывать, что анизоцитоз может быть связан с другими изменениями в общем анализе крови, такими как анемия или лейкопения, что может дополнительно усложнить клиническую картину и повлиять на прогноз. Например, при наличии анемии, вызванной дефицитом железа, анизоцитоз может указывать на необходимость более тщательного обследования для выявления причин недостатка железа и его коррекции.
В заключение, анизоцитоз тромбоцитов является важным клиническим маркером, который требует внимательного анализа и интерпретации в контексте общего состояния пациента. Прогноз и последствия анизоцитоза зависят от его причины, степени выраженности и наличия сопутствующих заболеваний, что подчеркивает необходимость комплексного подхода к диагностике и лечению данного состояния.